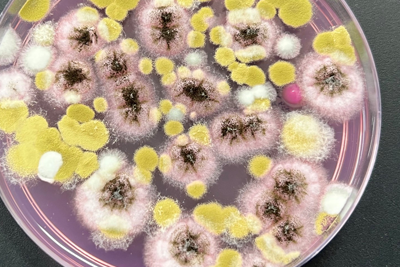
Mould Testing

Environment Testing

The Eurofins | Environment Testing network of laboratories across New Zealand offers a nationwide water quality monitoring, contaminated land testing and hygiene and air testing service, with industry-leading turn-around-times and pricing. Our broad testing scope, accredited by IANZ to ISO/IEC17025 and supported by the latest analytical methods, allows us to test for a range of contaminants in water, soil, air, waste and other products - including asbestos, methamphetamine, and inorganic and organic contaminants.
Our team of experts partners with environmental consultants, councils and managers of landfills and other industrial facilities, to test for a broad scope of emerging contaminants, such as: Pharmaceuticals and Personal Care Products (PPCPs) in water, and Perfluorinated compounds (PFAS) in matrices including soils, sediments, waters, and biota.
Services |Specialty Analysis